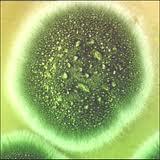
Astuce de la semaine n° 26

En hiver, neige et pluie sont de la partie!
En hiver, neige et pluie sont de la partie!Pour éviter que vos bacs en bois prennent l'humidité, installez sous les pieds de petites cales ou des briquettes pour surélever vos jardinières.
L'air qui circule entre le fond en bois et le sol évite les moisissures.
Au printemps, lors du nettoyage, remettez-les au sol !
Etre informé de nouveaux articles grâce au flux rss, abonnez-vous ! http://feeds.feedburner.com/LeJardinDePascaline

